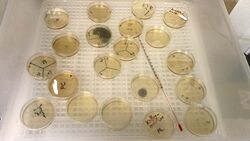

Nachrichten März 2018

Basketball AG für Klassen 5+6 startet nach den Osterferien!
Wir freuen uns sehr, nach den Osterferien die Kooperation mit dem FC Schalke 04 Basketball wieder aufnehmen zu können und eine AG für Schülerinnen und Schüler der Jahrgänge 5 und 6 anzubieten. Diese AG wird Montags in der Zeit von 15:15 Uhr bis 16:45 Uhr in unserer Halle stattfinden, zum ersten Mal am 9.4.2018. Ein Trainer von Schalke wird die AG leiten.
Weiterlesen … Basketball AG für Klassen 5+6 startet nach den Osterferien!

5 neue Eingangsklassen im Sommer
Nach Abschluss der Beratungen zum diesjährigen Anmeldeverfahren für den Jahrgang 5 steht fest, dass das Leibniz im Sommer fünf neue Eingangsklassen bildet. Insgesamt haben sich 133 Schülerinnen und Schüler angemeldet. Alle werden aufgenommen. Eine der neuen Klassen wird als bilinguale Englischklasse geführt, sodass auch alle bilingualen Anmeldewünsche erfüllt werden können.
Pillen, Pulsschlag und Prothesen - Dechemax-Wettbewerb
Recht einfach bekämpfen wir heutzutage Krankheiten, die für die Menschen noch vor hundert Jahren den sicheren Tod bedeutet hätten. Ein paar Leibniz-Schüler haben sich von DECHEMAX in die Forschungslabore und in die Apotheken von gestern und heute entführen lassen, wo Chemiker, Biotechnologen und Pharmazeuten neue Medikamente entwickeln.
Weiterlesen … Pillen, Pulsschlag und Prothesen - Dechemax-Wettbewerb

Kohlenstaub Und Sternenasche - Projektkurs on Stage
Am Freitag, 04.05.2018 im MZR von 14:00 – 15:30 Uhr werden die besten Arbeiten aus den beiden Projektkursen „Astrophysik“ und „Geschichte des Ruhrgebiets“ der Schulgemeinde und allen Interessierten vorgestellt. Physik in Science-fiction Filmen, die Geschichte des Leibniz, die Lichtverschmutzung unseres Nachthimmels, ein Blick auf das Rotlichtmilieu versprechen einen unvergesslichen Nachmittag im wissenschaftlichen Glanz.
Weiterlesen … Kohlenstaub Und Sternenasche - Projektkurs on Stage

Abiturienten aufgepasst - Erwerb des MINT-EC-Zertifikats
Seit diesem Schuljahr (2017/18) können wir besondere Leistungen unserer Abiturienten/innen im MINT-Bereich mit dem MINT-EC-Zertifikat auszeichnen. Diese Auszeichung können Abiturientinnen und Abiturienten erhalten, die sich über ihre gesamte Schullaufbahn hinweg über den Unterricht hinaus im MINT-Bereich engagiert haben.
Weiterlesen … Abiturienten aufgepasst - Erwerb des MINT-EC-Zertifikats

Leibniz-Team im Landesfinale unter den besten 6 in NRW
Am Mittwoch, 7.3.2018, erlebte das Mädchen Basketballteam einen Höhepunkt im Basketball – das Landesfinale. Dort traten aus allen Regierungsbezirken die besten Mannschaften an, um den Vertreter des Landes NRW auszuspielen und damit das Ticket zum Bundesfinale nach Berlin zu lösen.
Weiterlesen … Leibniz-Team im Landesfinale unter den besten 6 in NRW